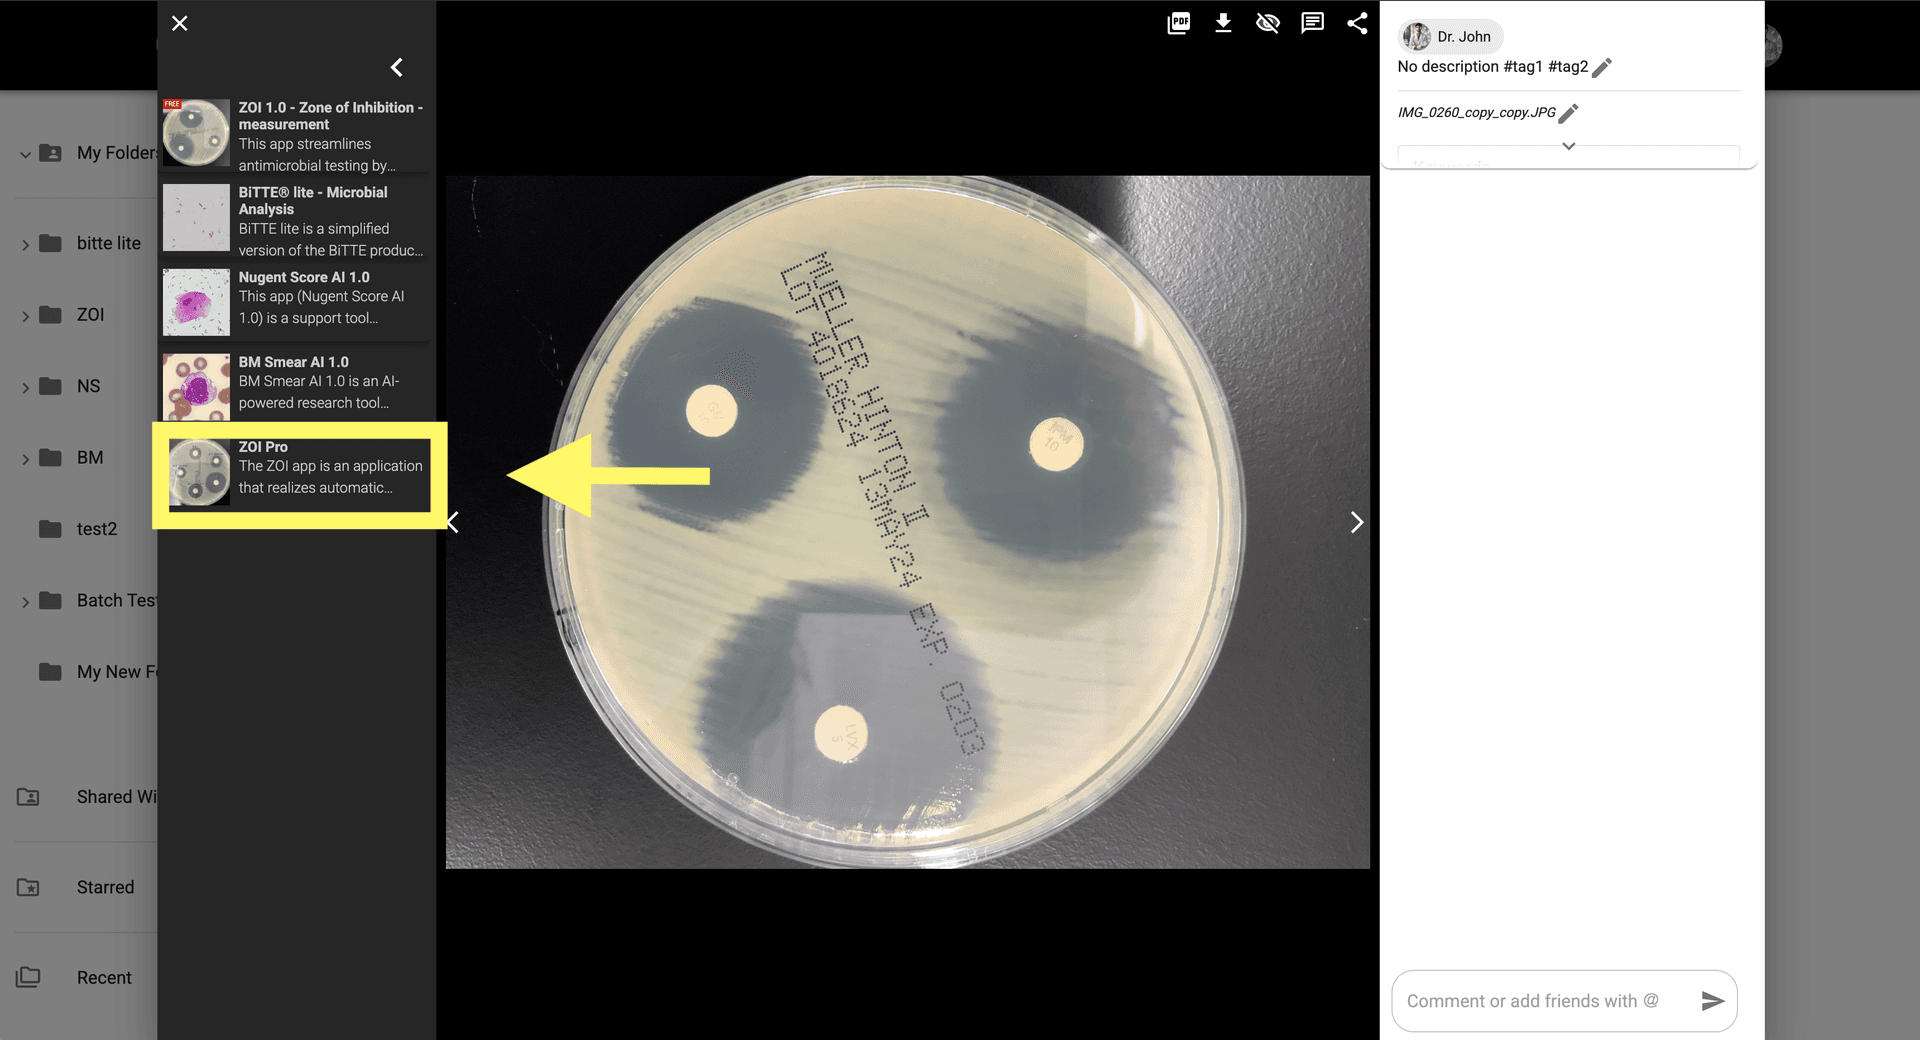
Step 2 image about Cara menggunakan ZOI Pro tutorial Step 2: Klik pada Ikon ZOI Pro untuk membuka pengaturan aplikasi untuk analisis lanjutan.
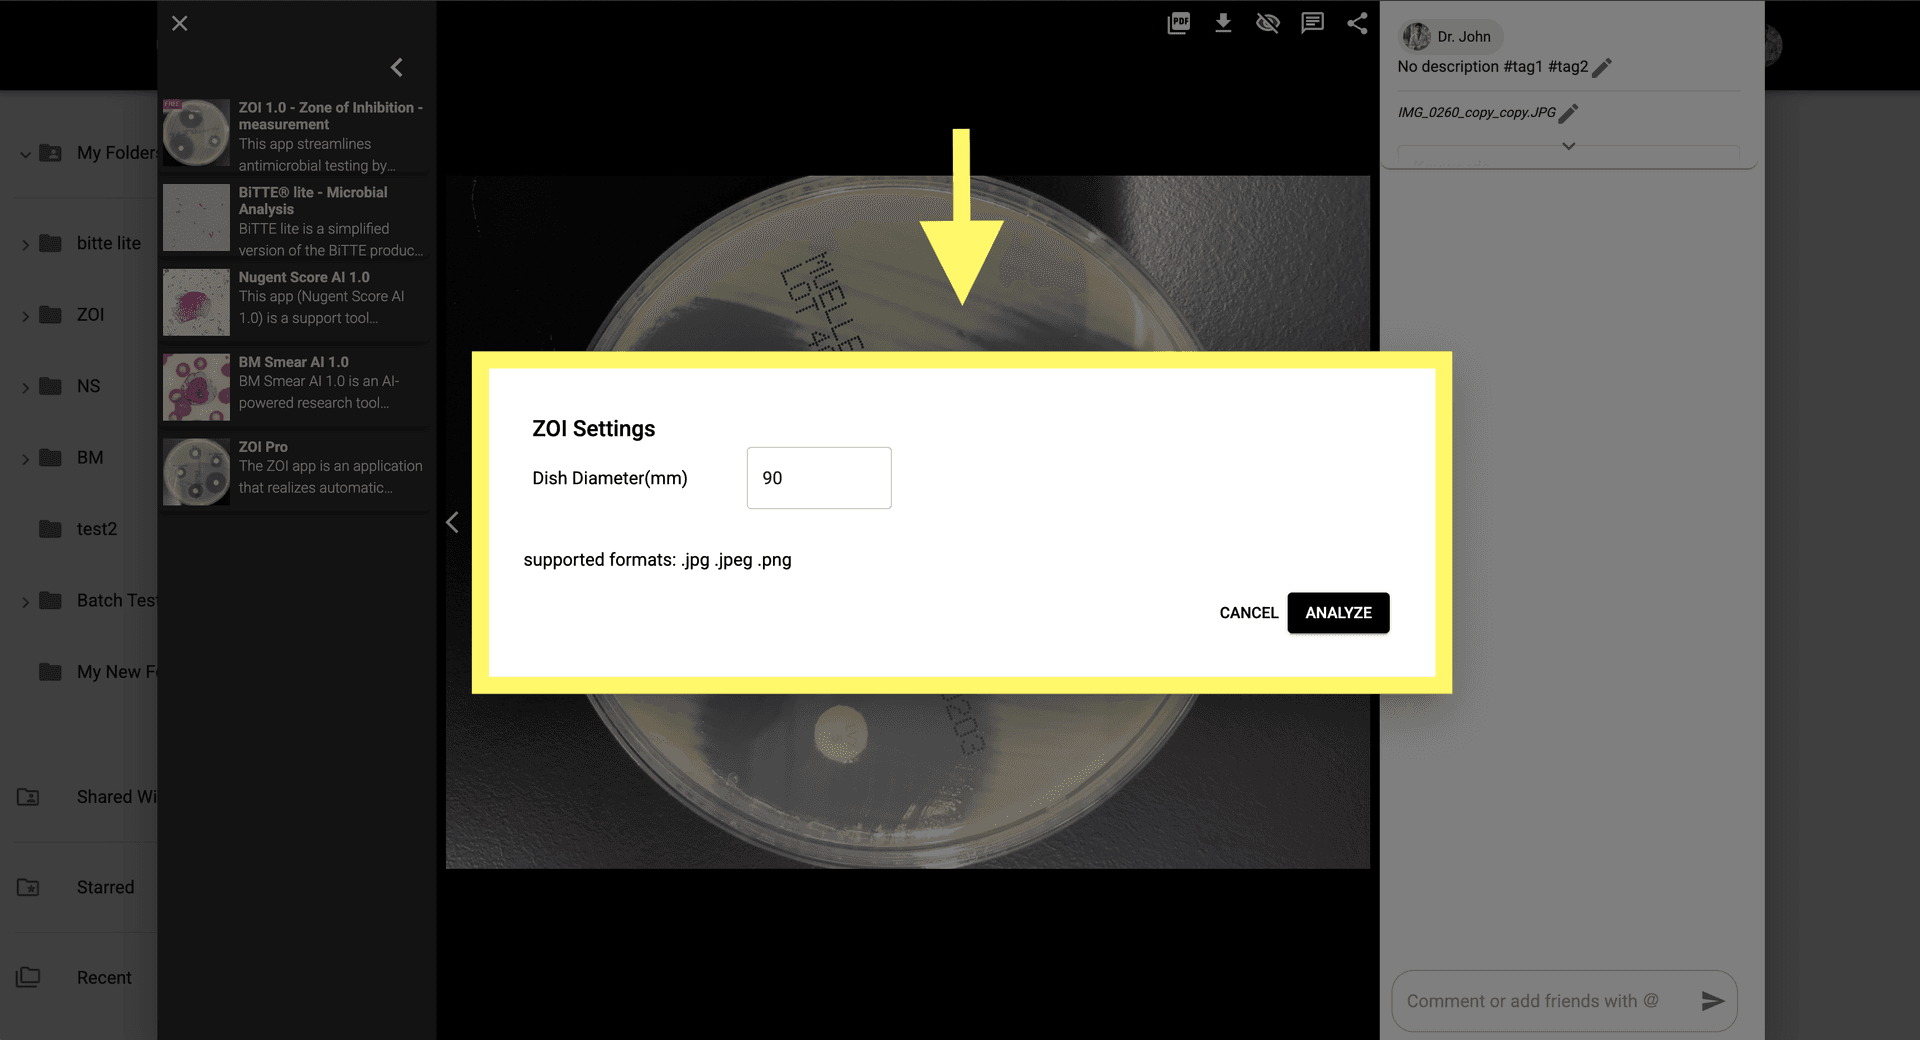
Step 3 image about Cara menggunakan ZOI Pro tutorial Step 3: Masukkan parameter untuk deteksi cakram antibiotik, pengukuran ukuran zona, dan lainnya.
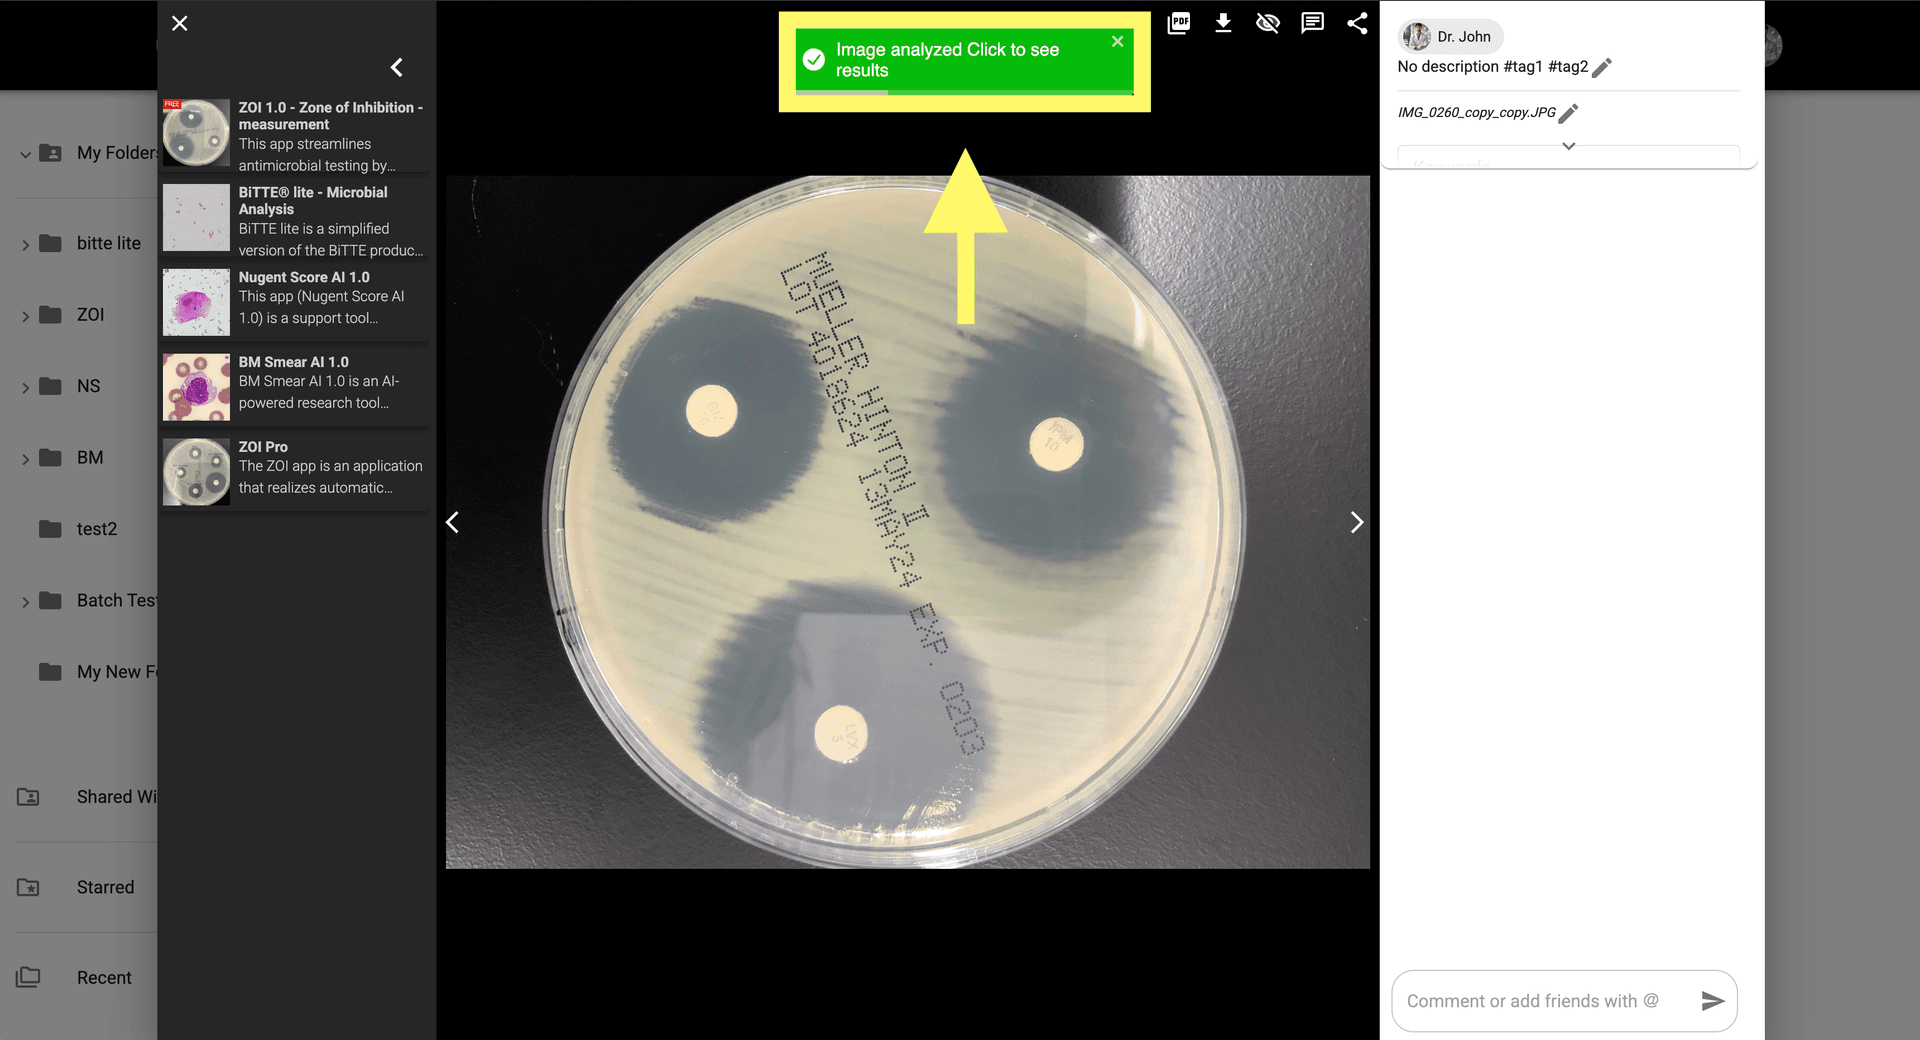
Step 5 image about Cara menggunakan ZOI Pro tutorial Step 5: Periksa hasil analisis di modal gambar atau buka gambar yang dihasilkan di galeri.
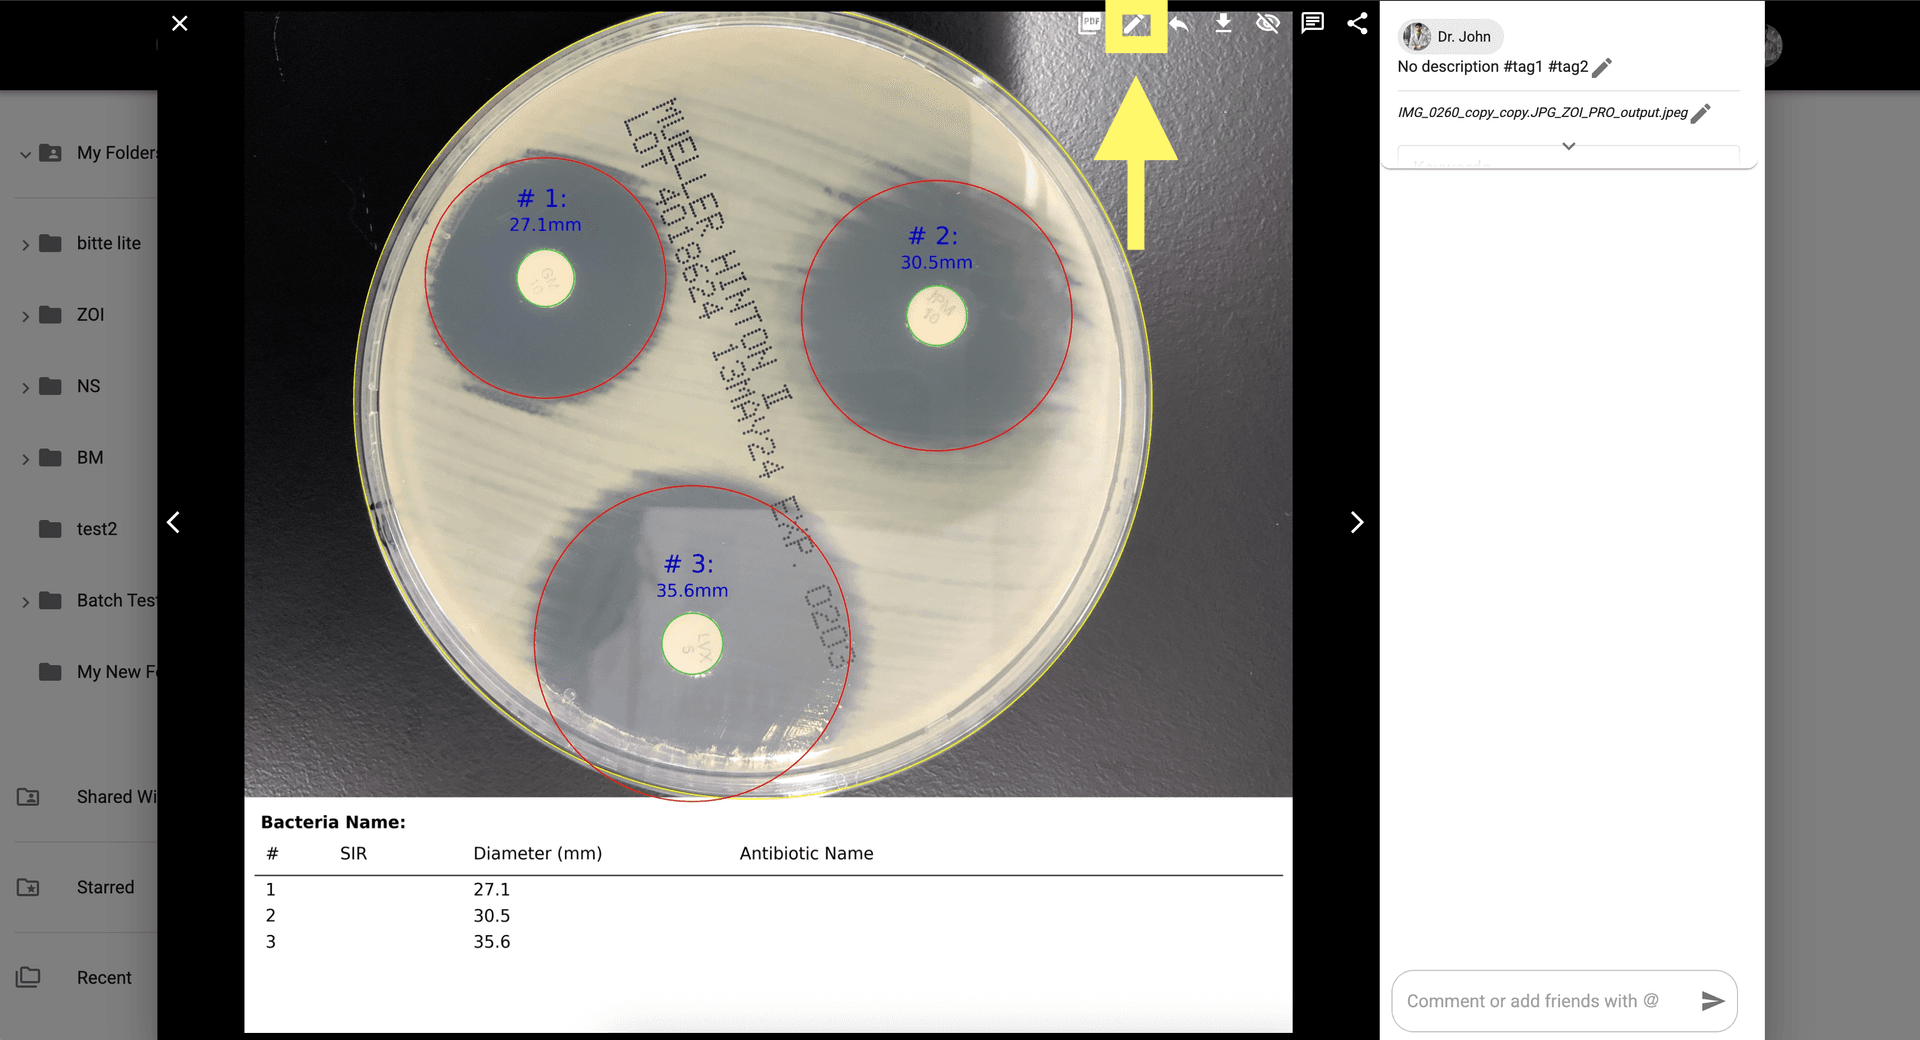
Step 6 image about Cara menggunakan ZOI Pro tutorial Step 6: Untuk penyesuaian manual, klik 'Tampilkan Koreksi AI' di kanan atas modal.
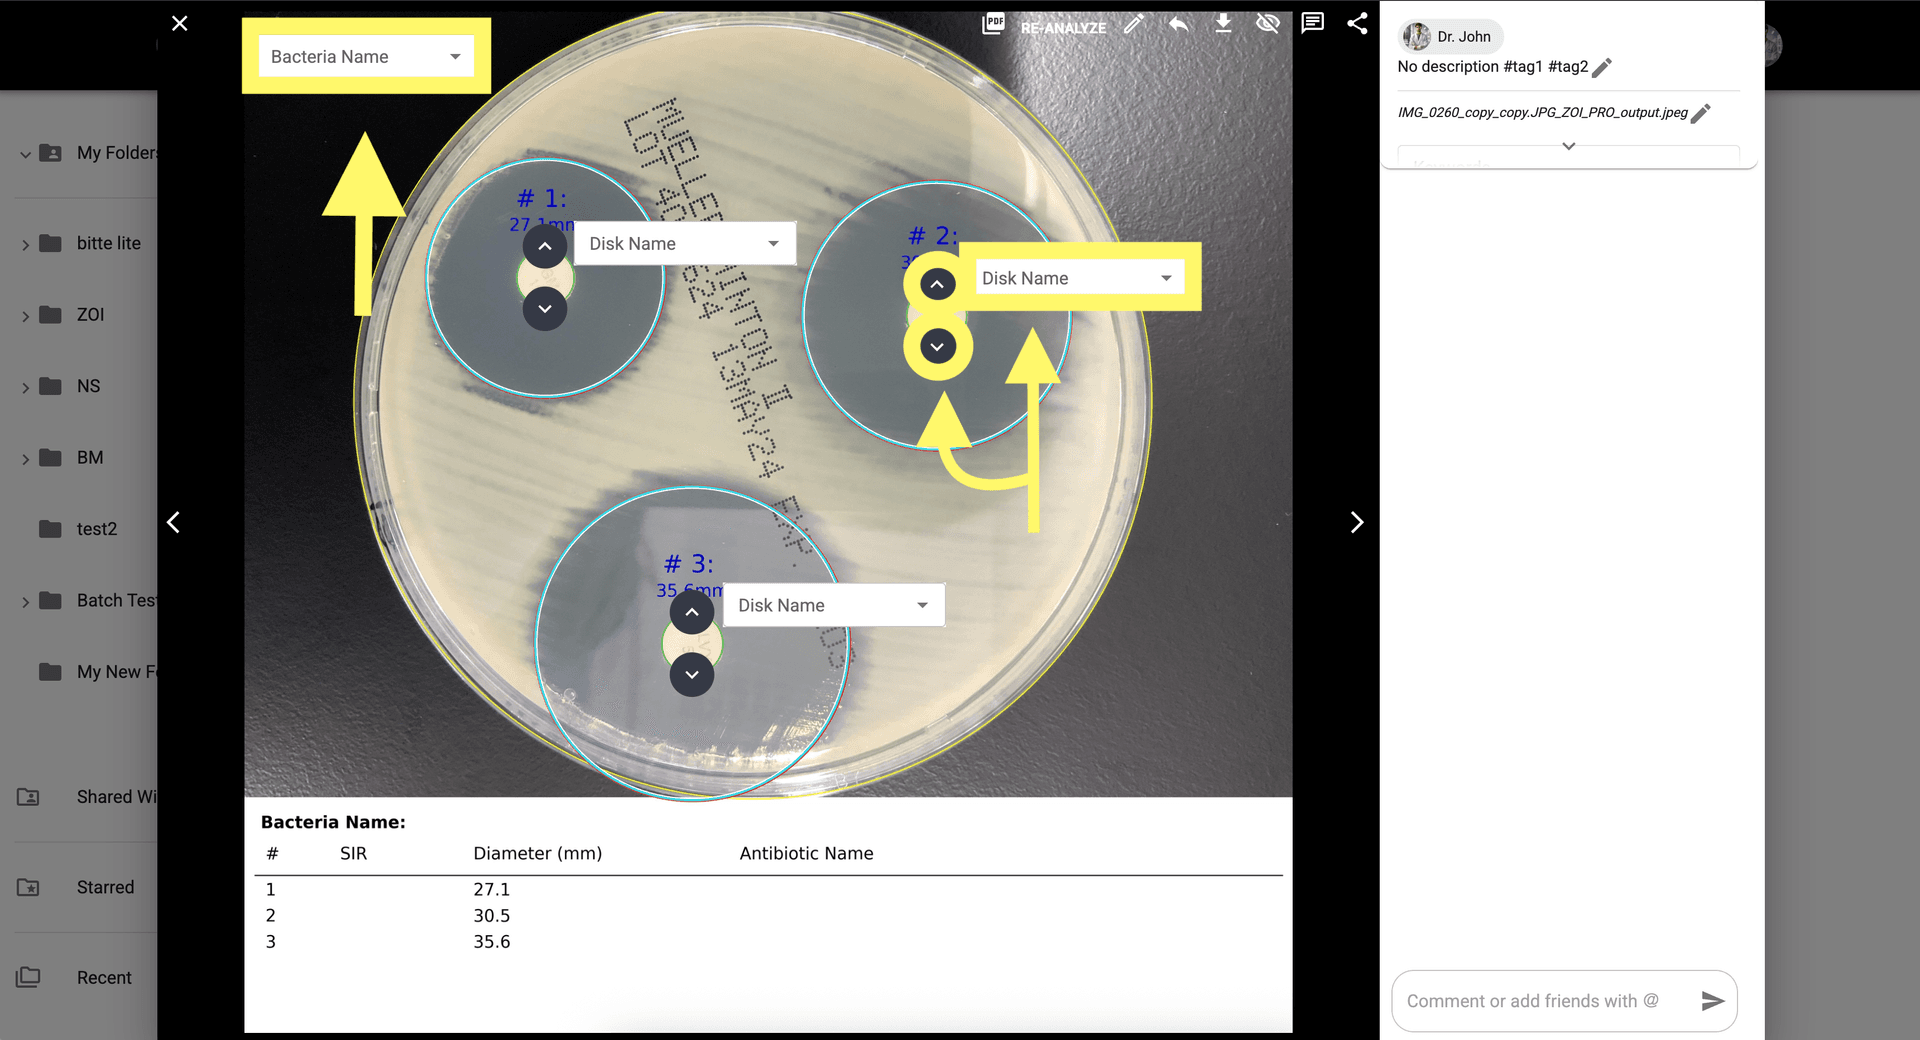
Step 7 image about Cara menggunakan ZOI Pro tutorial Step 7: Sesuaikan area ZOI secara manual dan atur Nama Bakteri atau Cakram/Antibiotik untuk perhitungan SIR.
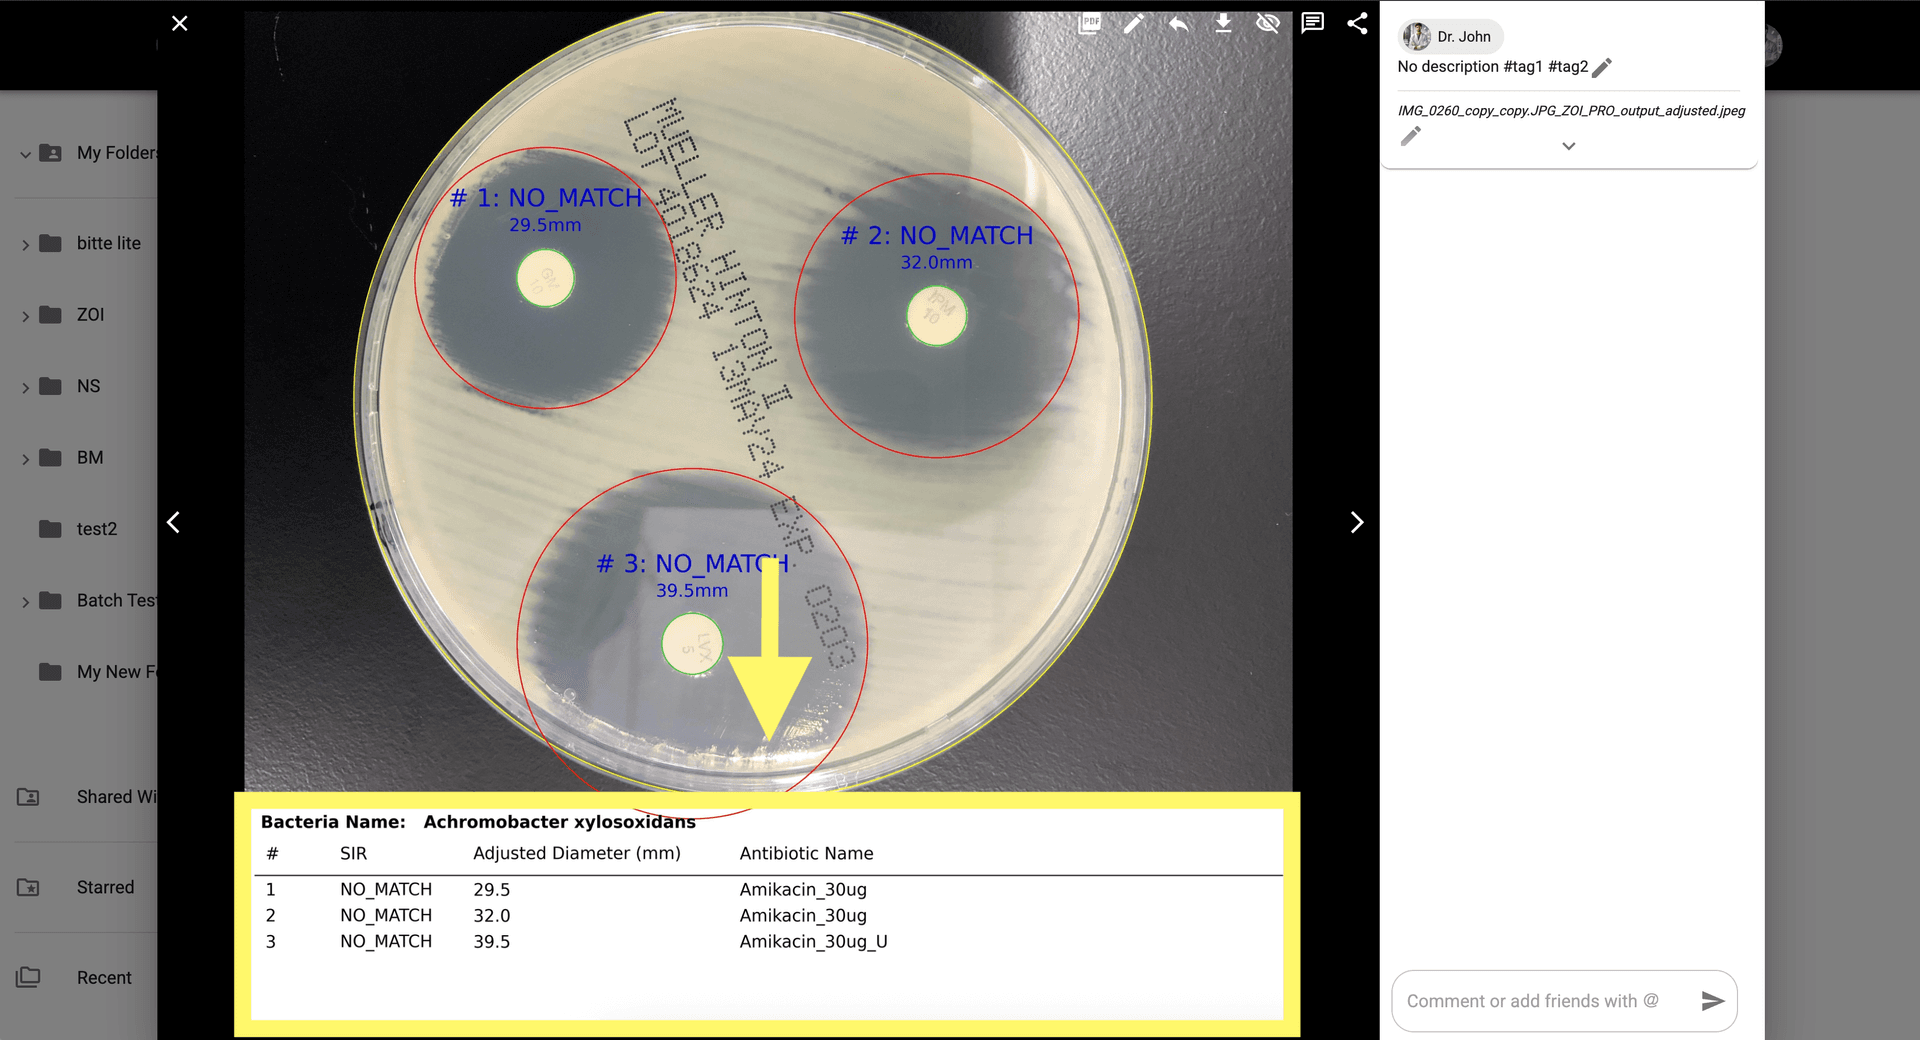
Step 9 image about Cara menggunakan ZOI Pro tutorial Step 9: Setelah dianalisis ulang, tinjau SIR, Diameter yang Disesuaikan, dan Nama Antibiotik di bagian bawah modal.

Cara menggunakan ZOI Pro
Menyelami lebih dalam analisis zona inhibisi yang komprehensif menggunakan ZOI Pro. Metode ini mirip dengan Antibiogram, menggunakan cawan Petri dan agar Mueller-Hinton untuk pengukuran sensitivitas atau resistensi yang kuat dari strain bakteri yang dianalisis.
Dari galeri, buka gambar ZOI Pro. Jika Anda memerlukan gambar contoh, unduh di sini.di sini
Klik pada Ikon ZOI Pro untuk membuka pengaturan aplikasi untuk analisis lanjutan.
Masukkan parameter untuk deteksi cakram antibiotik, pengukuran ukuran zona, dan lainnya.
Klik 'Analisis' untuk memulai proses AI lanjutan, yang akan mengukur ZOI.

Periksa hasil analisis di modal gambar atau buka gambar yang dihasilkan di galeri.
Untuk penyesuaian manual, klik 'Tampilkan Koreksi AI' di kanan atas modal.
Sesuaikan area ZOI secara manual dan atur Nama Bakteri atau Cakram/Antibiotik untuk perhitungan SIR.
Klik 'Analisis Ulang' setelah Anda puas dengan koreksi manual.

Setelah dianalisis ulang, tinjau SIR, Diameter yang Disesuaikan, dan Nama Antibiotik di bagian bawah modal.